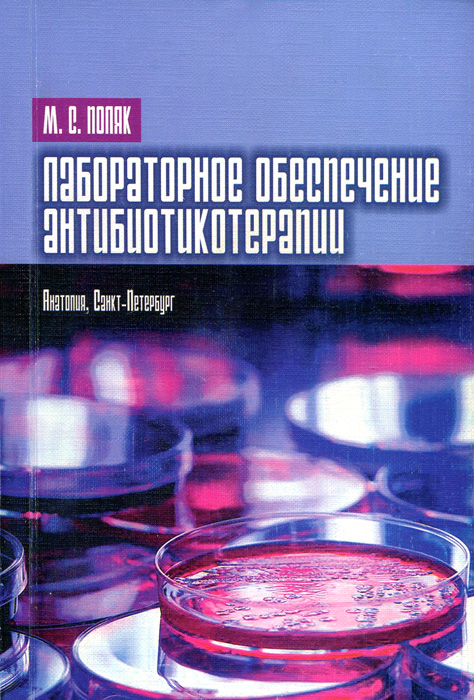

18+
На сайте представлено только описание и выходные данные книги «Лабораторное обеспечение антибиотикотерапии М. С. Поляк». Сайт не является распространителем книги. Сайт не предоставляет возможности купить, читать онлайн или скачать бесплатно книгу «Лабораторное обеспечение антибиотикотерапии М. С. Поляк». Сайт предназначен для лиц старше 18 лет. Если вам не исполнилось 18 лет - незамедлительно покиньте сайт. Оставаясь на сайте вы подтверждаете, что вам исполнилось 18 лет.
Незаконное потребление наркотических средств, психотропных веществ, их аналогов причиняет вред здоровью, их незаконный оборот запрещен и влечет установленную законодательством ответственность
Книга является важным дополнением к ранее опубликованной автором монографии "Антибиотикотерапия. Теория и практика". В новом издании рассматриваются лабораторные методы, результаты применения которых способны существенно расширить основания для правильного выбора антимикробного лекарственного средства, его дозы и пути введения в организм, особенно при терапии больных с тяжелой патологией инфекционной природы. Акцент сделан на методологии, которая доступна любой микробиологической службе лечебного учреждения. Среди рассматриваемых методических приемов определение чувствительности микроорганизмов к бактерицидному (летальному) и сочетанному действию антибиотиков, определение активности бета-лактамаз грамотрицательных бактерий, в т. ч. не улавливаемой стандартными методами анализа, определение чувствительности к антибиотикам облигатно анаэробных бактерий и др.
Книга предназначена для клинических микробиологов, клинических фармакологов и врачей, интересующихся лабораторным обеспечением определения лечебного потенциала антимикробных лекарственных средств. Это и многое другое вы найдете в книге Лабораторное обеспечение антибиотикотерапии (М. С. Поляк)
| Полное название книги | М. С. Поляк Лабораторное обеспечение антибиотикотерапии |
| Тип | Книга |
| Автор | М. С. Поляк |
| Категории | Книги, Медицина и здоровье. ЗОЖ |
| ISBN | 9785745200472 |
| Возрастное ограничение | 18 |
| Издательство | Анатолия |
| Год | 2012 |
| Название транслитом | laboratornoe-obespechenie-antibiotikoterapii-m-s-polyak |
| Просмотров | 5 |
| Рейтинг izbe.ru | 0,0 |

Мари Мур

Брук Лин

Конкордия Антарова

Дэниел Киз

Абрахам Вергезе

Аида Синицына

Вадим Зеланд

Сергей Лукьяненко

Роберт Грин

Виктор Дашкевич

Роман Прокофьев

Пауло Коэльо